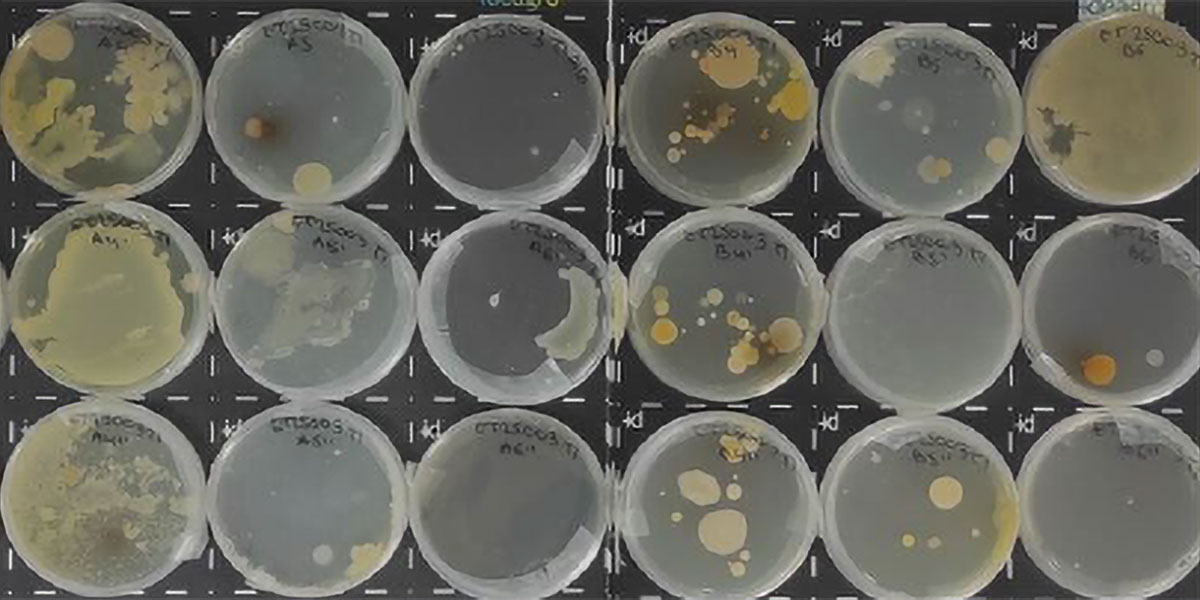

Introducción
La eficiencia productiva de los cultivos depende cada vez más del correcto funcionamiento del sistema suelo–planta–microbioma. En este contexto, los bioestimulantes prebióticos emergen como una herramienta clave para mejorar tanto la fisiología vegetal como la actividad biológica del suelo, favoreciendo sistemas agrícolas más eficientes y resilientes.
Agriful se posiciona dentro de esta nueva generación de bioestimulantes con una doble funcionalidad demostrada: bioestimulación directa del cultivo y activación prebiótica del microbioma del suelo, potenciando además la eficacia de los microorganismos agrícolas aplicados.
Bioestimulación vegetal: bases fisiológicas y agronómicas
Los bioestimulantes agrícolas modernos actúan modulando procesos fisiológicos clave en la planta, especialmente en etapas tempranas del desarrollo.
Gracias a su formulación basada en aminoácidos, materia orgánica y un cluster de moléculas bioactivas, Agriful promueve:
- estimulación del desarrollo radicular.
- incremento de la actividad metabólica de la raíz.
- mayor exploración del volumen de suelo.
- mejora en la absorción de agua y nutrientes.
Desde el punto de vista fisiológico, una raíz más activa y funcional permite una mejor sincronización entre la demanda del cultivo y la disponibilidad de nutrientes, lo que se traduce en plantas más vigorosas y con mayor potencial productivo.
Este efecto bioestimulante directo ha sido ampliamente contrastado en ensayos de campo, mostrando respuestas consistentes en vigor vegetativo y rendimiento en diferentes cultivos y condiciones edafoclimáticas.
El concepto de prebiótico del suelo en agricultura
Más allá del efecto directo sobre la planta, Agriful actúa como prebiótico del suelo, un concepto cada vez más relevante en la gestión agronómica moderna.
Un prebiótico agrícola se define como un conjunto de sustancias capaces de:
- servir como fuente de carbono y energía para la microbiota beneficiosa.
- estimular su actividad metabólica.
- favorecer la proliferación de poblaciones microbianas funcionales en la rizosfera.
A diferencia de los inoculantes, el prebiótico no introduce microorganismos, sino que optimiza el entorno edáfico para que la microbiología nativa y aplicada pueda desarrollarse de forma más eficiente.
Evidencia científica: activación del microbioma y fertilidad biológica del suelo
En ensayos específicos de suelo, la aplicación de Agriful mostró un impacto significativo sobre indicadores clave de salud edáfica.

Actividad enzimática del suelo
Se registraron incrementos en enzimas directamente relacionadas con la actividad microbiana:
- Deshidrogenasa: +19 %
Indicador directo del metabolismo microbiano activo.
- β-glucosidasa: +9 %
Asociada a la mineralización de la materia orgánica.
- Fosfatasa: +8 %
Relacionada con la disponibilidad de fósforo asimilable.
Índice Biológico de Fertilidad (IBF)
El IBF aumentó un 12 %, reflejando un sistema edáfico más activo, estable y funcional.
Biodiversidad microbiana
La aplicación del bioestimulante prebiótico provocó un incremento del 357 % en bacterias mesófilas totales, junto con un aumento de grupos taxonómicos clave como:
- actinobacterias.
- proteobacterias.
- géneros funcionales del grupo Bacillus.
Estos resultados confirman la capacidad de Agriful para activar el microbioma del suelo, base fundamental de la fertilidad biológica.
Impacto agronómico: eficiencia nutricional y rendimiento
La activación conjunta de la planta y del microbioma se traduce en beneficios agronómicos medibles.
En un ensayo realizado en cultivo de habas, la aplicación de Agriful produjo:
- incremento del 14 % en la eficiencia de uso del nitrógeno (NUE).
- aumento del 27 % en el rendimiento de cosecha.

Estos datos ponen de manifiesto que la bioestimulación prebiótica:
- mejora la dinámica del nitrógeno en el suelo.
- reduce pérdidas.
- y aumenta la productividad sin necesidad de incrementar insumos.
Sinergia con microorganismos agrícolas: un enfoque complementario
El uso de microorganismos beneficiosos es una estrategia consolidada en agricultura. Sin embargo, su eficacia depende en gran medida de las condiciones biológicas del suelo.
En ensayos donde Agriful se combinó con productos microbianos de referencia basados en Bacillus, se observó que:
- los microorganismos aplicados expresaron mejor su potencial.
- se incrementó la biomasa radicular y aérea.
- la respuesta del cultivo fue más estable y consistente.
Es importante destacar que esta sinergia no es específica de un tipo de microorganismo, sino que se basa en la mejora del entorno edáfico. Por ello, el efecto prebiótico de Agriful es compatible y complementario con cualquiera de los productos a base de microorganismos de referencia disponibles en el mercado.
Implicaciones para una agricultura más sostenible
La integración de bioestimulación vegetal y activación del microbioma del suelo permite avanzar hacia sistemas productivos más sostenibles:
- mayor eficiencia nutricional.
- mejor aprovechamiento de fertilizantes.
- reducción de la variabilidad de respuesta de los biológicos.
- incremento de la resiliencia del cultivo frente al estrés.
Este enfoque responde a las demandas actuales de una agricultura basada en conocimiento, eficiencia y sostenibilidad.
Conclusión
Agriful representa un enfoque integral dentro de la bioestimulación moderna, al combinar:
- estimulación fisiológica directa del cultivo.
- efecto prebiótico sobre el microbioma del suelo.
- y sinergia con microorganismos agrícolas.
La evidencia científica y los resultados en campo confirman que la activación previa del sistema suelo–planta es un paso clave para maximizar la eficiencia productiva y el rendimiento de los cultivos.
Si deseas ampliar información sobre el uso de bioestimulantes prebióticos y su impacto en la eficiencia productiva y la sostenibilidad agrícola, completa el formulario y nuestro equipo técnico se pondrá en contacto contigo con información adaptada a tus necesidades.